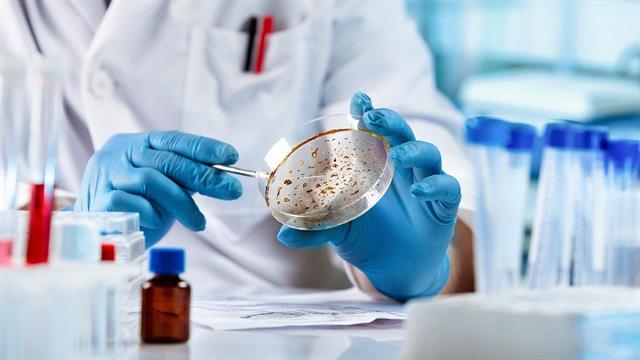
Tα κορυφαία ενδημικά παθογόνα για τα οποία χρειάζονται επειγόντως νέα εμβόλια

Μια νέα μελέτη του Παγκόσμιου Οργανισμού Υγείας (ΠΟΥ) που δημοσιεύθηκε στο eBioMedicine κατονομάζει 17 παθογόνους παράγοντες που προκαλούν τακτικά ασθένειες στις κοινότητες και αυτό τις καθιστά κορυφαίες προτεραιότητες για την ανάπτυξη νέων εμβολίων. Η μελέτη του ΠΟΥ είναι η πρώτη παγκόσμια προσπάθεια για συστηματική ιεράρχηση ενδημικών παθογόνων με βάση κριτήρια που περιελάμβαναν την επιβάρυνση της περιοχής από ασθένειες, τον κίνδυνο μικροβιακής αντοχής και τον κοινωνικοοικονομικό αντίκτυπο.
Η μελέτη επιβεβαιώνει μακροχρόνιες προτεραιότητες για την έρευνα και ανάπτυξη εμβολίων (R&D), συμπεριλαμβανομένων των ασθενειών HIV, της ελονοσίας και της φυματίωσης – τρεις ασθένειες που συλλογικά αφαιρούν σχεδόν 2,5 εκατομμύρια ζωές κάθε χρόνο.
Η μελέτη προσδιορίζει επίσης παθογόνους παράγοντες όπως ο στρεπτόκοκκος της ομάδας Α και η Klebsiella pneumoniae ως κορυφαίες προτεραιότητες ελέγχου της νόσου σε όλες τις περιοχές, υπογραμμίζοντας την επείγουσα ανάγκη ανάπτυξης νέων εμβολίων για παθογόνα ολοένα και πιο ανθεκτικά στα αντιμικροβιακά.
«Πολύ συχνά οι παγκόσμιες αποφάσεις για νέα εμβόλια οδηγούνται αποκλειστικά από την απόδοση της επένδυσης και όχι από τον αριθμό των ζωών που θα μπορούσαν να σωθούν στις πιο ευάλωτες κοινότητες», δήλωσε η Δρ Kate O'Brien, Διευθύντρια του Τμήματος Ανοσοποίησης, Εμβόλια και Βιολογικά, τμήμα στον ΠΟΥ.
Αυτή η νέα παγκόσμια λίστα προτεραιότητας του ΠΟΥ για ενδημικά παθογόνα για την Ε&Α εμβολίων υποστηρίζει τον στόχο του Ανοσοποιητικού Προγράμματος 2030 να διασφαλίσει ότι όλοι, σε όλες τις περιοχές, μπορούν να επωφεληθούν από εμβόλια που τους προστατεύουν από σοβαρές ασθένειες.
Αυτή η παγκόσμια άσκηση ιεράρχησης των ενδημικών παθογόνων, συμπληρώνει το Σχέδιο Ε&Α του ΠΟΥ για επιδημίες, το οποίο εντόπισε παθογόνα προτεραιότητας που θα μπορούσαν να προκαλέσουν μελλοντικές επιδημίες ή πανδημίες, όπως η COVID-19 ή το σοβαρό οξύ αναπνευστικό σύνδρομο (SARS).
Κατάλογος ενδημικών παθογόνων προτεραιότητας του ΠΟΥ. Τα εμβόλια για αυτά τα παθογόνα βρίσκονται σε διαφορετικά στάδια ανάπτυξης.
Παθογόνα όπου απαιτείται έρευνα εμβολίων
- Στρεπτόκοκκος ομάδας Α
- Ιός ηπατίτιδας C
- HIV-1
- Klebsiella pneumoniae
Παθογόνα όπου τα εμβόλια πρέπει να αναπτυχθούν περαιτέρω
- Κυτομεγαλοϊός
- Ιός γρίπης (ευρεία προστατευτικό εμβόλιο)
- Είδος Leishmania
- Μη τυφοειδής σαλμονέλα
- Νοροϊός
- Plasmodium falciparum (ελονοσία)
- Είδος Shigella
- Staphylococcus aureus
Παθογόνα όπου τα εμβόλια πλησιάζουν την έγκριση, τη σύσταση πολιτικής ή την εισαγωγή
- Ιός δάγκειου πυρετού
- Στρεπτόκοκκος ομάδας Β
- Εξωεντερικό παθογόνο E. coli
- Mycobacterium tuberculosis
- Αναπνευστικός συγκυτιακός ιός (RSV).
Πηγές:
www.who.int
Ειδήσεις υγείας σήμερα
Οικογένεια: Το κρίσιμο μέτρο που έχει μείνει στο...ράφι
Mέσος όρος 69% το νοσοκομειακό clawback
Φάρμακο: Καθυστερήσεις και εμπόδια στην πρόσβαση των ασθενών
Επιστροφή των ΗΠΑ στην εμβολιαστική συμμαχία
Επιστροφή των ΗΠΑ στην εμβολιαστική συμμαχία Οι γονείς στη Γερμανία εμπιστεύονται τους εμβολιασμούς
Οι γονείς στη Γερμανία εμπιστεύονται τους εμβολιασμούς Μήνυμα υπέρ της πρόληψης και του εμβολιασμού από Άδωνι Γεωργιάδη και Ειρήνη Αγαπηδάκη
Μήνυμα υπέρ της πρόληψης και του εμβολιασμού από Άδωνι Γεωργιάδη και Ειρήνη Αγαπηδάκη Ενημερωτική εκστρατεία για τον διά βίου εμβολιασμό
Ενημερωτική εκστρατεία για τον διά βίου εμβολιασμό Εμβόλια ενηλίκων: Γιατί η προστασία δεν σταματά στην παιδική ηλικία
Εμβόλια ενηλίκων: Γιατί η προστασία δεν σταματά στην παιδική ηλικία EMA: Συμβουλευτική ομάδα για αύξηση της εμπιστοσύνης των πολιτών στα εμβόλια
EMA: Συμβουλευτική ομάδα για αύξηση της εμπιστοσύνης των πολιτών στα εμβόλια Οικογένεια: Το κρίσιμο μέτρο που έχει μείνει στο...ράφι
Οικογένεια: Το κρίσιμο μέτρο που έχει μείνει στο...ράφι Φάρμακο: Καθυστερήσεις και εμπόδια στην πρόσβαση των ασθενών
Φάρμακο: Καθυστερήσεις και εμπόδια στην πρόσβαση των ασθενών "Το γάλα της λήθης": Έγκριση νέου αναισθητικού στις ΗΠΑ
"Το γάλα της λήθης": Έγκριση νέου αναισθητικού στις ΗΠΑ Μπορούν τρόφιμα να ενισχύσουν την απορρόφηση της βιταμίνης D;
Μπορούν τρόφιμα να ενισχύσουν την απορρόφηση της βιταμίνης D; Ρύζι, πατάτες και ζυμαρικά: Ποιο είναι χειρότερο για το σάκχαρο;
Ρύζι, πατάτες και ζυμαρικά: Ποιο είναι χειρότερο για το σάκχαρο; Με ποιες τροφές να συνδυάζω ρύζι, πατάτες και ζυμαρικά για να μην αυξάνεται απότομα το σάκχαρο
Με ποιες τροφές να συνδυάζω ρύζι, πατάτες και ζυμαρικά για να μην αυξάνεται απότομα το σάκχαρο Pharmathen: Βαθιά κρίση και μηδενισμός αποτίμησης από funds της Partners
Pharmathen: Βαθιά κρίση και μηδενισμός αποτίμησης από funds της Partners Καρπούζι: Ποια είναι τα οφέλη του στην υγεία
Καρπούζι: Ποια είναι τα οφέλη του στην υγεία Ιατρικός Σύλλογος Θεσσαλονίκης: Σαρωτική επικράτηση της ΕΝΟ.ΣΥ. - Ν.Ι.Κ.Ι.
Ιατρικός Σύλλογος Θεσσαλονίκης: Σαρωτική επικράτηση της ΕΝΟ.ΣΥ. - Ν.Ι.Κ.Ι. Φαρμακοβιομηχανίες σκέφτονται να χτυπήσουν την πόρτα της Εθνικής Αρχής Διαφάνειας
Φαρμακοβιομηχανίες σκέφτονται να χτυπήσουν την πόρτα της Εθνικής Αρχής Διαφάνειας Οι απρόσμενες συνέπειες της ολοκληρωτικής παράλειψης της ζάχαρης από τη διατροφή [μελέτη]
Οι απρόσμενες συνέπειες της ολοκληρωτικής παράλειψης της ζάχαρης από τη διατροφή [μελέτη] 9 εξακριβωμένα οφέλη του κολοκυθόσπορου
9 εξακριβωμένα οφέλη του κολοκυθόσπορου